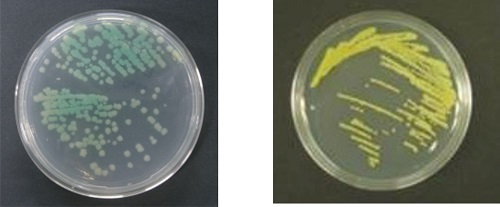

細菌由来糖脂質の構造と生合成に関わる研究
近年、細菌(バクテリア)由来の糖脂質は微生物と動植物との相互作用において重要な働きをしており、自然免疫とよばれる免疫システムに係わっていることがわかってきました。当研究室では主に細菌が作る糖脂質について、化学構造と生合成遺伝子を調べ、これを基にして、免疫活性や保湿活性などの有用活性を有する糖脂質の生産を目指した研究を行っています。これ以外にも、難分解性物質の分解菌やその酵素の研究など、細菌を用いた幅広い研究を展開しています。
《詳しい研究紹介はこちら》
【研究紹介】(外部サイトnote)
【細菌の糖脂質でワクチンを改良】(外部サイトnote)(2021/3/4New!)
(Internet explorer以外のブラウザをご使用ください。)
《その他の研究紹介リンク》
FMヨコハマ『ヨコハマウォーカーラジオ 教えて学院』 (2017/5/26)
卒業研究
2020年度
・海洋性細菌Aureispira maritimaが有するセラミドとセラミド含有脂質の化学的性状
・真正火落ち菌および関連菌株の培地による菌体脂肪酸の変化
・Campylobacter jejuniの2種類の脂肪酸転移酵素遺伝子導入による大腸菌リピドA構造の改変
・植物由来乳酸菌のG+C含量および菌体脂質の分析
2019年度
・Aureispira属菌種のセラミド様脂質に関する研究
・コリスチン耐性に関わるリピドA構造修飾の阻害剤の探索
・植物由来新規乳酸菌の分類学的性状の検討
・Campylobacter jejuni由来脂肪酸転移酵素遺伝子の導入による大腸菌リピドA構造の改変
・Sphingomonas asaccharolytica由来オリゴ糖型GSLの精製と化学的性状の検討
・テレフタル酸分解菌のペプチドグリカンおよび脂質の分析
・火落ち菌および類縁乳酸菌の菌体脂肪酸とグリセロ糖脂質の分析
2018年度
・大腸菌リピドA 脂肪酸転移酵素遺伝子を利用した大腸菌リピドA構造の改変
・テレフタル酸分解菌のG+C含量の測定
・有機リン系化合物分解酵素の遺伝子破壊に必要とされるプラスミドの作製
・Aureispira marinaが産生するセラミド様脂質の化学構造の解析
・Bacteroides fragilis菌体脂質の化学分析
・Enterococcus faeciumが有する酸性糖脂質の精製と構造解析
・Bordetella属細菌のリポ多糖O抗原の構造解析
・Sphingomonas asaccharolytica由来オリゴ糖型スフィンゴ糖脂質の化学的性状
・スフィンゴモナス属細菌に導入可能なシャトルベクタープラスミドの修復
・Klebsiella pneumoniae脂肪酸転移酵素遺伝子の導入による大腸菌リピドA構造の改変
2017年度
・Caulobacter segnisが有するアルカリ分解に安定な菌体脂質の分析
・有機リン系化合物分解酵素の菌体外分泌量と保存方法の検討
・スフィンゴモナス科細菌への導入用に作製したシャトルベクターの機能の検討
・ポリエチレンテレフタレート分解菌分離のスクリーニング系の構築
・大腸菌リピドA脂肪酸転移酵素遺伝子破壊株を利用した改変リピドAの構造解析
・Enterococcus faecium由来酸性グリセロ糖脂質の化学構造解析
・Sphingomonas asaccharolytica由来スフィンゴ糖脂質の精製と構造解析
・Brevundimonas diminutaに含まれる菌体脂質の精製と質量分析
・Aureispira marina由来のセラミド様脂質の化学的性状の検討
・乳酸菌ペプチドグリカンにおけるアミノ酸組成と免疫活性の関連性